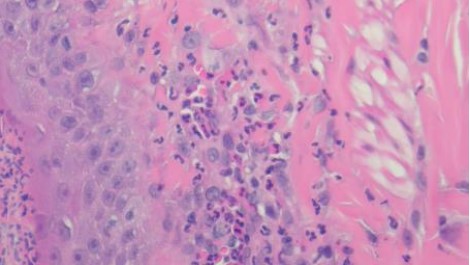

貓落葉型天皰瘡的疑似病例討論
貓落葉型天皰瘡的疑似病例討論
梅西動物醫院 温琮斐 獸醫師
第一章、 文獻探討
落葉型天皰瘡 (Pemphigus foliaceus, PF)是貓咪最常見的自體免疫皮膚疾病,因免疫球蛋白攻擊顆粒層 (stratum granlosum)內角化細胞間的連結,導致原發性角質層下膿皰 (pustules)以及棘狀層溶解 (acantholysis)。然而目前對貓落葉型天皰瘡的了解遠不及人類與狗,2020年Levy等人發現和角化細胞膜結合的抗角化細胞抗體 (anti-keratinocyte IgG),但確切的標的蛋白仍未釐清(Levy et al., 2020; Preziosi, 2019)。罹患落葉型天皰瘡的貓咪會先出現紅斑 (erythematous macule) (Peterson and McKay, 2010),但這個病灶很快就會進展成膿皰因此很難在此階段就做出診斷。不同於細菌性毛囊炎引發局部膿皰,天皰瘡引起的膿皰會影響多個毛囊。當脆弱的膿皰破裂就會變成硬皮 (crusts),硬皮下則常常有潰瘍 (erosions)病灶。和其他動物相似,罹患落葉型天皰瘡的貓咪皮膚病灶多位於頭部、耳朵及腳掌,身體其他部位的病灶也可能出現(Jordan et al., 2019; Simpson and Burton, 2013)。皮膚病灶的部位以及細胞學抹片可初步懷疑貓咪罹患此疾病,需要組織病理學確診,以及排除其他相似病灶的疾病 (Preziosi, 2019)。近年來,許多以不同藥物治療貓咪落葉型天皰瘡的文獻發表,而類固醇仍然是最常使用的藥物,但治療成效並不穩定。其他藥物包括chlorambucil, aurothioglucose, ciclosporin, azathioprine以及oclaticinib (Bizikova and Burrows, 2019; Carrasco et al., 2021)。
第二章、 病例摘要
病患為十歲九個月已絕育公米克斯貓,主訴是精神食慾下降以及長期皮膚病。半年前開始右側腋下出現脫毛與潮紅的病灶,在附近的動物醫院就診,懷疑是過敏,開立外用藥軟膏持續治療,症狀改善。三個月前出現搔癢症狀,雙側耳殼出現硬皮病灶及脫毛,到另一家動物醫院求診,此後定期到動物醫院打針以及口服抗生素治療。根據飼主描述打完針劑之後搔癢症狀緩解,但大約間隔三天後又會復發,因此持續注射針劑控制。當週開始打針也難以控制搔癢症狀,診療之動物醫院採樣診斷為酵母菌感染,將針劑停掉開立抗黴菌藥物以及洗劑治療。然而患貓耳朵、腋下以及乳頭周圍的病灶沒有明顯變化,且出現精神食慾下降的症狀。當天理學檢發現查貓咪精神沉鬱,督普勒血壓為90毫米汞柱,其餘生理數值無明顯異常。右側腋窩、雙側耳殼以及右側第二對乳頭周圍都有硬皮與潰瘍病灶如圖一所示。
根據病史、理學檢查發現精神沉鬱、低血壓以及全血球計數發現嗜中性球數量6050/μL、淋巴球數量2130/μL、嗜酸性球數量980/μL,以及檢測可體松濃度低於0.5μg/dL懷疑二次性醫源性腎上腺功能低下症。停止所有口服藥,開立prednisolone 0.6mg/kg sid、amoxicillin 20mg/kg bid。由於病灶處可見大量酵母菌感染,開立外用chlorhexidine及醋酸刷洗病灶處。
.jpg)

A B C
圖一:A, 右側腋窩潰瘍病灶,B, 左耳殼硬皮病灶,C, 右側第二對乳頭周圍潰瘍病灶。
執行治療計畫後患貓精神食慾以及皮膚病灶皆有改善,但於雙側耳殼與右側腋窩持續仍出現新的硬皮病灶如圖二所示,因此將硬皮移除後做壓片檢查,細胞學發現棘狀層溶解細胞 (acantholytic cells)如圖三所示。根據病灶位置、細胞學發現棘狀層溶解細胞、先前使用抗生素症狀無明顯改善病史,懷疑為落葉型天皰瘡因而建議飼主採樣做組織病理學檢查。


A B


圖二:A, 右側腋窩病灶,BC, 分別為左右耳病灶,D, 軀幹部位病灶,可見少量新生的硬皮。


A B
圖三:移除硬皮後壓片A, 可見大量是中性球以及棘狀層溶解細胞 (Modified Wright; X400) B, 高倍下可見退行性變化的嗜中性球、雙球菌以及棘狀層溶解細胞
(Modified Wright; oil)。
組織病理結果為化膿性嗜酸球性真皮炎,如圖四所示。排除感染的問題,提高prednisolone劑量到3mg/kg sid,兩週後硬皮病灶消失、搔癢症狀緩解,開始逐漸減量類固醇,目前1mg/kg qod狀況良好如圖五所示,持續治療。


A B

C D
圖四:A, 檢體為表皮層到真皮層組織,少部分表層皮下脂肪有涵蓋在檢體內。B, 表皮結構完整,表面有大量的壞死細胞碎片、片狀角質、脫落的角化細胞覆蓋或是形成沒有破裂的膿皰結構,皮膚糜爛但局限於表皮,基底膜完整。C, 真皮層輕微水腫,有少量到中等量、零散分布的發炎細胞浸潤,細胞有略微分布表層真皮或是毛囊腺體周圍的傾向,但不明顯。D, 浸潤的細胞以嗜中性球、嗜酸性球以及肥大細胞為主,血管內也可見到數量明顯增加的嗜中性球及嗜酸性球,皆為分化成熟沒有惡性特徵。D, 表皮層中有見到一顆凋亡細胞 (apoptotic cell),但周邊沒有淋巴細胞包圍。E, 此外毛囊腺體的結構完整,沒有破裂,毛囊內也沒有見到細菌、黴菌或是寄生蟲。以特殊染色B&B檢查檢體,沒有見到細菌病原。



圖五:持續減量類固醇劑量,目前是prednisolone1mg/kg qod。可見患貓無新生皮膚病灶,無搔癢症狀。
第三章、 討論
貓咪落葉型天皰瘡是原發性角質下病變,典型症狀包括角質層下的膿皰、二次性表層潰瘍及硬皮。此疾病並沒有年齡、品種及性別特異性,好發於中年 (中位數五到六歲)貓咪,目前尚沒有發現明確會導致此疾病的誘發因子。病灶最常發生在耳朵和頭部、臉部,也會出現在四肢腳掌、肉墊、乳頭周圍、肛門周圍等位置,有些病患則會出現搔癢、發燒等全身性的症狀 (Bizikova and Burrows, 2019; Jordan et al., 2019; Preziosi et al., 2003)。本病患就診時主要為雙側外耳、腋窩、軀幹以及乳頭周圍多發局部的硬皮以及潰瘍病灶,且同時有搔癢的症狀。
貓咪很少出現醫源性的腎上腺功能亢進的問題,但文獻顯示貓咪長期使用類固醇仍可能出現庫興氏症,而做ACTH刺激試驗則會是因腎上腺萎縮、導致功能低下的檢驗結果 (Ferasin, 2001; Smith et al., 2002)。本病患於就診時出現精神沉鬱、血壓偏低、沒有明顯緊迫性血球相以及可體松濃度低於0.5μg/dL,懷疑為二次性醫源性腎上腺功能低下。且在投與類固醇治療後症狀改善。
會引起貓咪原發性角質下膿皰及棘狀層溶解的疾病並不多,除了落葉型天皰瘡之外,教科書作者提過貓皮癬菌症 (dermatophytosis)也可能出現類似的膿皰,但棘狀層溶解的現象應該不會那麼顯著。此外狗和人因為金黃色葡萄球菌或假中間葡萄球菌引起的水泡性魚鱗癬樣角化過度 (bullous impetigo)也會出現類似症狀,在貓咪則尚沒有相關研究(Olivry and Linder, 2009)。本病例患貓出現硬皮與潰瘍的病灶位置位於雙側耳殼、體壁與乳頭周圍,且在細胞學下發現棘狀層溶解細胞。雖然組織病理學下沒有發現棘狀層溶解的現象,但亦以特殊染色排除細菌感染。因而高度懷疑為落葉型天皰瘡。
落葉型天皰瘡的治療仍是以2-3mg/kg/d的類固醇為主流,持續使用兩週再逐漸減量。貓咪對prednisolone的使用率遠高於prednisone,首選用藥為prednisolone或是triamcinolone。回溯性研究顯示多數的貓單獨使用prednisolone都可以在八週內控制住疾病 (remission),且減量到中位數1.2mg/kg/w的劑量,且有14%的貓最後可以停藥。本病例使用prednisolone 3mg/kg/d作為起始劑量,於兩週後症狀緩解並開始減量。目前減量到1mg/kg/d疾病仍控制良好。
未來在繼續減量的過程中若出現復發的病灶或是因用藥出現的其他不良反應,比如類固醇引起的糖尿病等,則會考慮合併使用其他免疫抑制藥。Cyclosporine以及Oclacitinib相較於其他免疫抑制藥有較低的副作用與不良反應,或許可以作為接下來用藥的首選。如果可以好好地減量到停掉類固醇就好了呢 (Carrasco et al., 2021; Preziosi, 2019)。
Bizikova, P., Burrows, A., 2019. Feline pemphigus foliaceus: original case series and a comprehensive literature review. BMC Vet Res 15, 22.
Carrasco, I., Martinez, M., Albinyana, G., 2021. Beneficial effect of oclacitinib in a case of feline pemphigus foliaceus. Vet Dermatol.
Ferasin, L., 2001. Iatrogenic hyperadrenocorticism in a cat following a short therapeutic course of methylprednisolone acetate. J Feline Med Surg 3, 87-93.
Jordan, T.J.M., Affolter, V.K., Outerbridge, C.A., Goodale, E.C., White, S.D., 2019. Clinicopathological findings and clinical outcomes in 49 cases of feline pemphigus foliaceus examined in Northern California, USA (1987-2017). Vet Dermatol 30, 209-e265.
Levy, B.J., Mamo, L.B., Bizikova, P., 2020. Detection of circulating anti-keratinocyte autoantibodies in feline pemphigus foliaceus. Vet Dermatol 31, 378-e100.
Olivry, T., Linder, K.E., 2009. Dermatoses affecting desmosomes in animals: a mechanistic review of acantholytic blistering skin diseases. Vet Dermatol 20, 313-326.
Peterson, A., McKay, L., 2010. Crusty cats: feline pemphigus foliaceus. Compend Contin Educ Vet 32, E1-4.
Preziosi, D.E., 2019. Feline Pemphigus Foliaceus. Vet Clin North Am Small Anim Pract 49, 95-104.
Preziosi, D.E., Goldschmidt, M.H., Greek, J.S., Jeffers, J.G., Shanley, K.S., Drobatz, K., Mauldin, E.A., 2003. Feline pemphigus foliaceus: a retrospective analysis of 57 cases. Vet Dermatol 14, 313-321.
Simpson, D.L., Burton, G.G., 2013. Use of prednisolone as monotherapy in the treatment of feline pemphigus foliaceus: a retrospective study of 37 cats. Vet Dermatol 24, 598-601, e143-594.
Smith, S.A., Freeman, L.C., Bagladi-Swanson, M., 2002. Hypercalcemia due to latrogenic secondary hypoadrenocorticism and diabetes mellitus in a cat. J Am Anim Hosp Assoc 38, 41-44.






